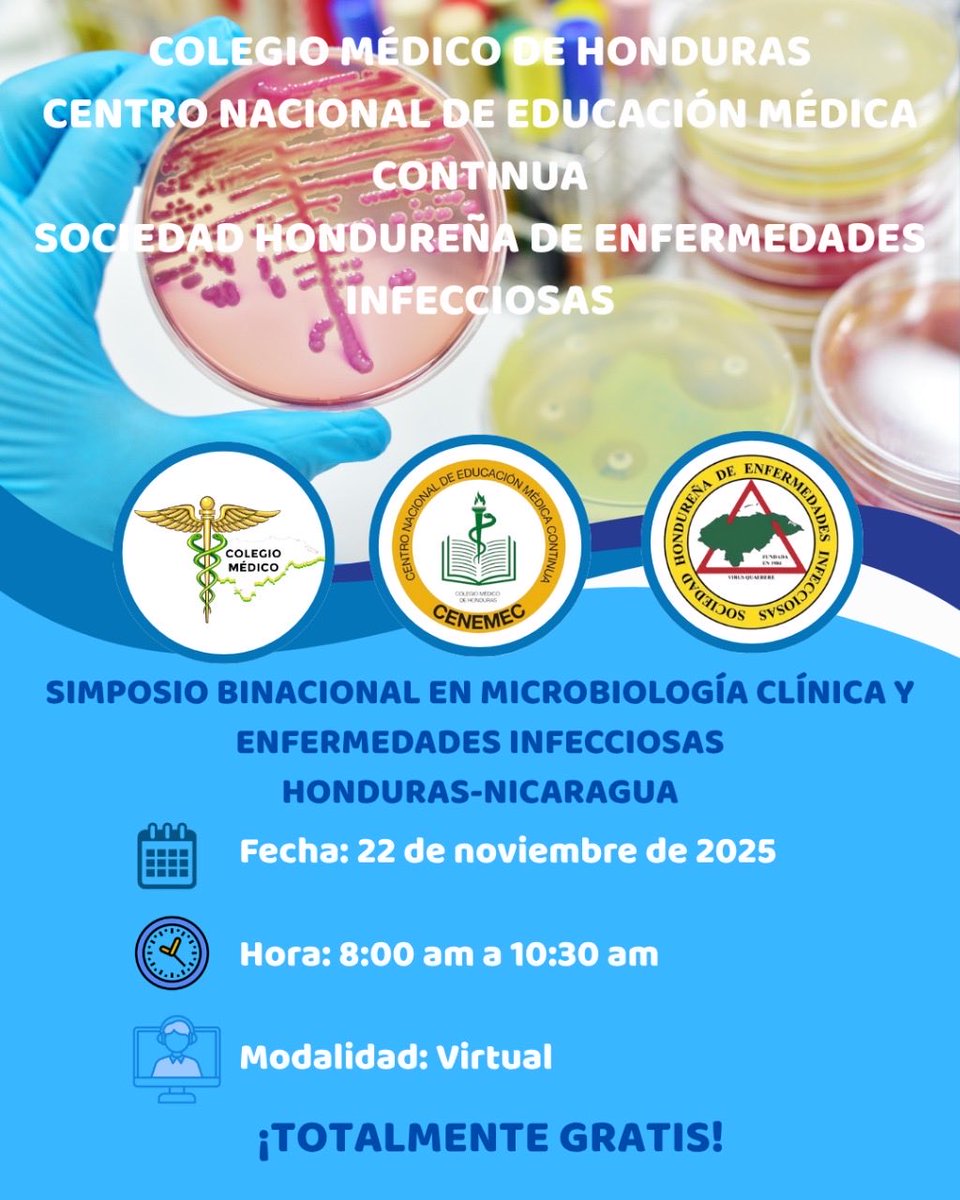
ACENCAI tweet media
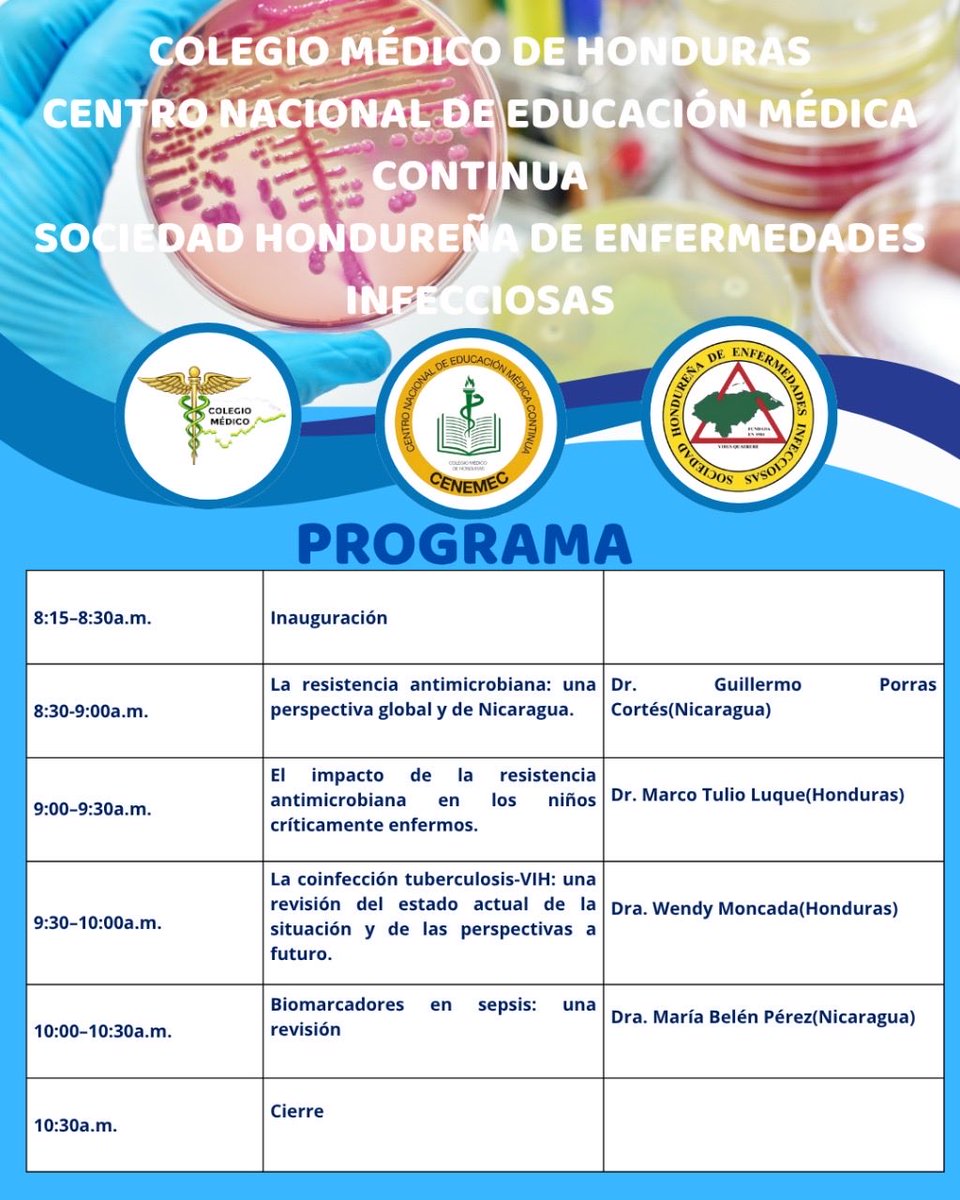
ACENCAI tweet media

🤧 ¿Sabías que toser o estornudar en el codo puede evitar la propagación de virus respiratorios?
Este pequeño gesto protege a quienes te rodean: en el trabajo, en casa, en el transporte.
✅ Simple. Efectivo. Necesario.
#ParaElContagio 👉 Tose y estornuda en el codo.
Español